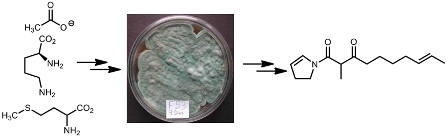

vol. 23, No. 10, 2012, p. 1767-1954
G-Protein-Coupled Receptors: the 2012 Nobel Prize in Chemistry
The Royal Swedish Academy of Sciences awarded the 2012 Nobel Prize in Chemistry to the U.S. researchers Robert J. Lefkowitz, from the Duke University Medical Center (North Carolina, USA) and to Brian K. Kobilka, from the Stanford University School of Medicine (California, USA) for their studies on the G-proteincoupled receptors (GPCRs).
(Read more at Editorial)
Suppression of the Hemolytic Effect of Mesoporous Silica Nanoparticles after Protein Corona Interaction: Independence of the Surface Microchemical Environment
Amauri J. Paula; Diego Stéfani T. Martinez; Roberto T. Araujo Júnior; Antonio G. Souza Filho; Oswaldo L. Alves
How to cite this article
The effects induced by nanoparticles interacting in biological fluids and with blood cells were determined by fine and selective chemical interactions between these materials in nanoscale and biomolecules. In this context, understanding and controlling these interactions will be crucial to pave the way towards the application of nanomaterials in nanomedicine and nanotoxicology. Details are discussed in the Article by Paula et al. on page 1807.
https://dx.doi.org/10.1590/S0103-50532012005000048
Editorial J. Braz. Chem. Soc. 2012, 23(10), 1767-1770
G-Protein-Coupled Receptors: the 2012 Nobel Prize in Chemistry
Adriano D. Andricopulo; Glaucius Oliva
How to cite this article
https://dx.doi.org/10.1590/S0103-50532012001000001
Articles J. Braz. Chem. Soc. 2012, 23(10), 1772-1775
Synthesis, Crystal Structure and Biological Activity of Novel Diester Cyclophanes
Pengfei Zhang; Bingqin Yang; Xianwen Fang; Zhao Cheng; Meipan Yang
How to cite this article

Several novel cyclophanes were synthesized by esterification reactions under high dilution conditions. Some of these compounds have low antifungal or antibacterial activities
https://dx.doi.org/10.1590/S0103-50532012005000045
J. Braz. Chem. Soc. 2012, 23(10), 1776-1782
Spatial Structure of Eugenia dysenterica Based on Essential Oil Chemovariations and Implications for Conservation and Management of the Genetic Diversity of its Populations
Eliane C. Vilela; Thays C. Carvalho; Alessandra R. Duarte; Ronaldo R. Naves; Suzana C. Santos; José C. Seraphinc; Pedro H. Ferri
How to cite this article

Essential oils were used to study the spatial structure of eight Eugenia dysenterica populations in central Brazilian Cerrado. Differential patterns can be explained by the distinct spatial rearrangement of the populations and may contribute to the species management and conservation based only on oil chemovariations
https://dx.doi.org/10.1590/S0103-50532012005000043
J. Braz. Chem. Soc. 2012, 23(10), 1783-1788
Biosynthesis of Two Dihydropyrrole-Polyketides from a Marine-Derived Penicillium citrinum
Stelamar Romminger; Eli F. Pimenta; Eduardo S. Nascimento; Antonio G. Ferreira; Roberto G. S. Berlinck
How to cite this article
Feeding experiments using 13C-labeled precursors were performed aim at investigating the biosynthesis of two dihydropyrrole-polyketides isolated from a marine-derived Penicillium citrinum. The results showed that the biosynthesis proceeds from acetate, methionine and ornithine
https://dx.doi.org/10.1590/S0103-50532012005000046
J. Braz. Chem. Soc. 2012, 23(10), 1789-1799
Probing Topological Electronic Effects in Catalysis: Thiophene Adsorption on NiMoS and CoMoS Clusters
Itamar Borges Jr.; Alexander M. Silva
How to cite this article

Thiophene adsorbed on NiMoS and CoMoS catalysts was studied with density functional theory and a topological approach to probe electronic modifications. The origin of the promoter effect, an enhancement of hydrodesulfurization activity due to weaking of metal-sulfur bond strengths, was explained
https://dx.doi.org/10.1590/S0103-50532012005000044
J. Braz. Chem. Soc. 2012, 23(10), 1800-1806
Determination of Sildenafil Citrate (Viagra®) in Various Pharmaceutical Formulations by Flow Injection Analysis with Multiple Pulse Amperometric Detection
Antônio Carlos V. Lopes Júnior; Rita de Cássia Silva Luz; Flávio S. Damos; Alexandre S. dos Santos; Diego L. Francoe; Wallans T. Pio dos Santos
How to cite this article

Fast and low-cost methodology for the determination of sildenafil in different types of pharmaceutical samples using a flow injection analysis (FIA) system with multiple pulse amperometric detection on a boron-doped diamond electrode is presented. Excellent reproducibility and high analytical frequency were obtained under these conditions
https://dx.doi.org/10.1590/S0103-50532012005000047
J. Braz. Chem. Soc. 2012, 23(10), 1807-1814
Suppression of the Hemolytic Effect of Mesoporous Silica Nanoparticles after Protein Corona Interaction: Independence of the Surface Microchemical Environment
Amauri J. Paula; Diego Stéfani T. Martinez; Roberto T. Araujo Júnior; Antonio G. Souza Filho; Oswaldo L. Alves
How to cite this article

Bare porous silica nanoparticles induce hemolysis in human red blood cells, while protein coated nanoparticles resulted from their interaction with blood plasma (the so called protein corona effect) completely prevent the hemolytic effect
https://dx.doi.org/10.1590/S0103-50532012005000048
J. Braz. Chem. Soc. 2012, 23(10), 1815-1822
Evaluation of Chemical Changes during Myrciaria cauliflora (Jabuticaba Fruit) Fermentation by 1H NMR Spectroscopy and Chemometric Analyses
Gilmara A. C. Fortes; Sara S. Naves; Pedro H. Ferri; Suzana C. Santos
How to cite this article

Metabolites were monitored during jabuticaba fermentation by 1H nuclear magnetic resonance and spectrophotometric assays. Multivariate methods revealed the influences of alcohols and organic acids on the extraction and stability of phenols and color properties
https://dx.doi.org/10.1590/S0103-50532012005000050
J. Braz. Chem. Soc. 2012, 23(10), 1823-1833
Influence of Abiotic Factors on the Chemical Composition of Copaiba Oil (Copaifera multijuga Hayne): Soil Composition, Seasonality and Diameter at Breast Height
Paula C. S. Barbosa; Raquel S. Medeiros; Paulo T. B. Sampaio; Gil Vieira; Larissa S. M. Wiedemanna; Valdir F. Veiga-Junior
How to cite this article

The chemical composition of copaiba oils (Copaifera multijuga Hayne) is affected by soil characteristics, but not seasonality or diameter at breast height (DBH). Cluster analysis shows that caryophyllene and its oxide form the main groups
https://dx.doi.org/10.1590/S0103-50532012005000049
J. Braz. Chem. Soc. 2012, 23(10), 1834-1838
Fast Determination of Naproxen in Pharmaceutical Formulations by Batch Injection Analysis with Pulsed Amperometric Detection
Jessica S. Stefano; Ana Paula de Lima; Rodrigo H. O. Montes; Eduardo M. Richter; Rodrigo A. A. Muñoz
How to cite this article

A fast method for naproxen determination in pharmaceutical formulations using batch injection analysis with pulsed amperometric detection is presented. High analytical frequency (90 h-1), satisfactory accuracy and low limit of detection (0.3 µmol L-1) were obtained
https://dx.doi.org/10.1590/S0103-50532012005000055
J. Braz. Chem. Soc. 2012, 23(10), 1839-1843
Synthesis of N-Substituted Phthalimidoalkyl 1H-1,2,3-Triazoles: a Molecular Diversity Combining Click Chemistry and Ultrasound Irradiation
Moara T. da Silva; Ronaldo N. de Oliveira; Wagner O. Valença; Fernanda C. G. Barbosa; Mauro G. da Silva; Celso A. Camara
How to cite this article

N-substituted phthalimidoalkyl 1H-1,2,3-triazoles were obtained in good-to-excellent yields (67-98%) through click chemistry protocol (Cu-AAC) at room temperature using DMF, Et3N under ultrasound irradiation
https://dx.doi.org/10.1590/S0103-50532012005000053
J. Braz. Chem. Soc. 2012, 23(10), 1844-1852
Chemotaxonomic Markers in Essential Oils of Hypenia (Mart. ex Benth.) R. Harley
Maria T. Faria; Deomar P. Costa; Eliane C. Vilela; Dalva G. Ribeiro; Heleno D. Ferreira; Suzana C. Santos; José C. Seraphind; Pedro H. Ferri
How to cite this article

Essential oil chemovariations in the genus Hypenia suggest that cadinanes and bicyclo-germacranes/aromadendranes are chemomarkers of sections Densiflorae and Laxiflorae, respectively
https://dx.doi.org/10.1590/S0103-50532012005000056
J. Braz. Chem. Soc. 2012, 23(10), 1853-1857
7,8-Secolignans from Schisandra neglecta and Their Anti-HIV-1 Activities
Xuemei Gao; Huaixue Mu; Ruirui Wang; Qiufen Hu; Liumeng Yang; Yongtang Zheng; Handong Sunb; Weilie Xiao
How to cite this article

Four new 7,8-secolignans (neglectahenols A-D) were isolated from leaves and stems of Schisandra neglecta, and neglectahenols A-D showed modest anti HIV-1 (human immuno-deficiency virus type 1) activities with therapeutic index (TI) values of 58.65, 26.36, 23.71 and 25.85, respectively
https://dx.doi.org/10.1590/S0103-50532012005000054
J. Braz. Chem. Soc. 2012, 23(10), 1858-1862
Synthesis of LaNiO3 Perovskite by the Modified Proteic Gel Method and Study of Catalytic Properties in the Syngas Production
José C. Santos; Marcelo J. B. Souza; Juan A. C. Ruiz; Dulce M. A. Melo; Maria E. Mesquita; Anne M. Garrido Pedrosa
How to cite this article

The temperature programmed reduction analysis of LaNiO3 and LaNiO3/Al2O3 showed that the Ni3+ of perovskite structure reduced in two steps and the peaks correspond to successive changes in the structure, which are related to reduction: Ni3+ to Ni2+ and Ni2+ to Ni0
https://dx.doi.org/10.1590/S0103-50532012005000052
J. Braz. Chem. Soc. 2012, 23(10), 1863-1870
Decolorization of Textile Dyes by Cyanobacteria
Maria Estela Silva-Stenico; Felipe D. P. Vieira; Diego B. Genuário; Caroline S. P. Silva; Luiz Alberto B. Moraes; Marli Fátima Fiore
How to cite this article

The use of cyanobacteria to decolorize and possibly to degrade eleven types of textile dyes was confirmed by mass spectrometry and resulted in completely textile dye remotion
https://dx.doi.org/10.1590/S0103-50532012005000058
J. Braz. Chem. Soc. 2012, 23(10), 1871-1879
Solar Radiation Effect on the Complexation Capacity of Aquatic Humic Substances with Metals
Camila A. Melo; Ana L. De Toffoli; Altair B. Moreira; Márcia C. Bisinoti
How to cite this article

The effect of solar radiation in the complexation capacity of aquatic humic substances (AHS) with Al3+, Cr3+, CrO42- and Ni2+ was evaluated. AHS were extracted and characterized employing conventional techniques
https://dx.doi.org/10.1590/S0103-50532012005000059
J. Braz. Chem. Soc. 2012, 23(10), 1880-1888
A Study of Asphaltene-Resin Interactions
Luiz C. C. Marques; Juliana O. Pereira; André D. Bueno; Valdo S. Marques; Elizabete F. Lucas; Claudia R. E. Mansur; André L. C. Machado; Gaspar González
How to cite this article

Asphaltic materials recovered from a subsea petroleum production flowline during a pigging operation in Santos Basin, Santa Catarina State, Brazil
https://dx.doi.org/10.1590/S0103-50532012005000060
J. Braz. Chem. Soc. 2012, 23(10), 1889-1894
Simultaneous Separation of Ciprofloxacin, Norfloxacin and Ofloxacin by Micellar Electrokinetic Chromatography
Gabriel Hancu; Aura Rusu; Brigitta Simon; Georgiana Boia; Árpád Gyéresi
How to cite this article

The article studies the electrophoretic behavior of the most frequently used fluoroquinolones (structurally related ciprofloxacin, norfloxacin and ofloxacin) in order to achieve their simultaneous separation from complex mixtures, by means of capillary zone electrophoresis respectively MEKC
https://dx.doi.org/10.1590/S0103-50532012005000057
J. Braz. Chem. Soc. 2012, 23(10), 1895-1899
A Simple Method to Evaluate, Correlate and Predict Boiling and Flash Points of Alkynes
Justin M. Godinho; Felix A. Carroll; Frank H. Quina
How to cite this article

Experimental boiling point numbers (YBP) of alkynes can be used to evaluate literature boiling point data, and YBP values calculated from simple structure counts can be used to predict alkyne boiling and flash points
https://dx.doi.org/10.1590/S0103-50532012005000064
J. Braz. Chem. Soc. 2012, 23(10), 1900-1906
Photocatalytic Decomposition of Phenol by Nanocomposite of ZnS Nanoparticles and Montmorillonite
Petr Praus; Jakub Matys; Ondřej Kozák
How to cite this article

ZnS nanoparticles were deposited on montmorillonite forming a stable nanocomposite, which was used as a catalyst for the photodecomposition of phenol. Reaction kinetics agreed with the pseudo-first reaction model confirming that the high amounts of hydroxyl radicals were produced. The catalytic activity of montmorillonite was not observed
https://dx.doi.org/10.1590/S0103-50532012005000063
J. Braz. Chem. Soc. 2012, 23(10), 1907-1914
Absolute Quantification of Fatty Acid and Proximate Composition of Cow and Goat Powdered Milks
Weliton P. Batiston; Swami A. Maruyama; Sandra T. M. Gomes; Jesuí V. Visentainer; Nilson E. de Souza; Makoto Matsushita
How to cite this article

Thermal processes applied in foods can lead to a loss of their nutritional quality due to the oxidation of their polyunsaturated fatty acids. Thus, the main objective of the present study is the absolute quantification of fatty acids from cow and goat powdered milks, through the application of gas chromatography with a flame ionization detector (GC-FID)
https://dx.doi.org/10.1590/S0103-50532012005000061
J. Braz. Chem. Soc. 2012, 23(10), 1915-1924
Seasonal Distribution of Airborne Trace Elements and Water-Soluble Ions in São Paulo Megacity, Brazil
Gisele O. Da Rocha; Pérola C. Vasconcellos; Simone G. Ávila; Davi Z. Souza; Eduardo A. O. Reis; Pedro V. Oliveira; Odon Sanchez-Ccoyllo
How to cite this article

This work describes the seasonal distribution of important constituents of PM10 particles (particulate matter less than 10 μm in diameter; major ions and trace elements) in Sao Paulo Megacity, Brazil. Predominant sources were fuel burning, biomass burning, gas-to-particle conversion and sea salt spray
https://dx.doi.org/10.1590/S0103-50532012005000062
J. Braz. Chem. Soc. 2012, 23(10), 1925-1932
Chemical Constituents from Chirita longgangensis var. hongyao with Inhibitory Activity against Porcine Respiratory and Reproductive Syndrome Virus
Yao Su; Jun-Long Bi; Yue-Hu Wang; Ying Tan; Jun Yang; Hong-Xin Liu; Wei Gu; Ge-Fen Yin; Chun-Lin Long
How to cite this article

Two new quinonoids and a new neolignan were isolated from stems of Chirita longgangensis var. hongyao
https://dx.doi.org/10.1590/S0103-50532012005000068
J. Braz. Chem. Soc. 2012, 23(10), 1933-1939
Flavonoids from the Leaves of Deguelia utilis (Leguminosae): Structural Elucidation and Neuroprotective Properties
Dalglish G. de Oliveira; Cecília M. C. de Almeida; Consuelo Y. Y. e Silva; Mara S. P. Arruda; Alberto C. Arruda; Dielly C. F. Lopes; Elizabeth S. Yamada; Edmar T. da Costa; Milton N. da Silva
How to cite this article

Five new compounds were isolated from the leaves of Deguelia utilis. A fraction containing all flavonoids was available to determine its neuroprotective action
https://dx.doi.org/10.1590/S0103-50532012005000065
J. Braz. Chem. Soc. 2012, 23(10), 1940-1950
Three New Labdanes Isolated from Eragrostis viscosa
N'Soki N. Sebastião; Nelson Fernandes; Liliana Vieira; António J. G. Mendonça; Jorge F. Gaspar; Celia Martins; José Rueff; Carlos Diakanamwa; Dina I. M. D. de Mendonça
How to cite this article

Three new labdanes methyl 8α,15-epoxylabdan-16β-oate, 8α,15-epoxylabdan-16β-ol and 8α,15-epoxy-16-norlabdan-13β-ol together with three known 8α,15-epoxylabdanes and two triterpenes were isolated from Eragrostis viscosa. 8α,15-Epoxylabdan-16β-ol was shown to be the most cytotoxic of the compounds tested
https://dx.doi.org/10.1590/S0103-50532012005000067
Short Reports J. Braz. Chem. Soc. 2012, 23(10), 1951-1954
Ionic Liquid Catalyzed Convenient Synthesis of Imidazo[1,2-a]quinoline under Sonic Condition
Devji S. Patel; Jemin R. Avalani; Dipak K. Raval
How to cite this article

https://dx.doi.org/10.1590/S0103-50532012005000051
Online version ISSN 1678-4790 Printed version ISSN 0103-5053
Journal of the Brazilian Chemical Society
JBCS Editorial and Publishing Office
University of Campinas - UNICAMP
13083-970 Campinas-SP, Brazil
Free access










